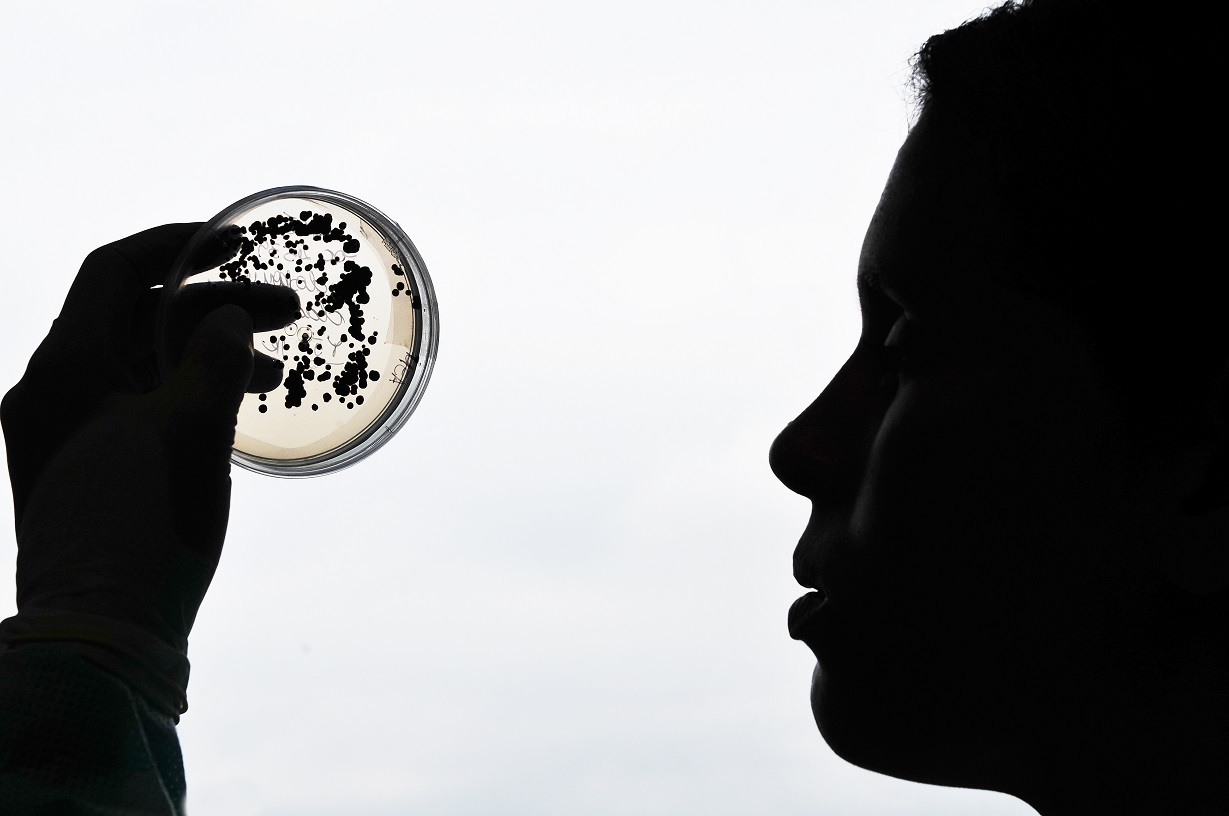
108948664_3199841593407313_1859307373164418312_o

O Instituto Oswaldo Cruz abre inscrições para 43 cursos livres
O Instituto Oswaldo Cruz / Fiocruz abriu inscrições para 43 cursos livres, entre eles “A arte no estudo de insetos”, “Divulgação Científica em Entomologia”, “Animes e mangás no ensino de Biociências e Saúde”, “Perfil das interações celulares e moleculares no sistema imune” e “Tópicos em saúde comunitária relacionados às doenças negligenciadas”.
A exigência de níveis de escolaridade é variada, o aluno deve verificar o curso que deseja fazer para saber as orientações para as inscrições, que vão até o dia 22 de julho.
Para ver as informações de todos os cursos: bit.ly/32oiKkD
